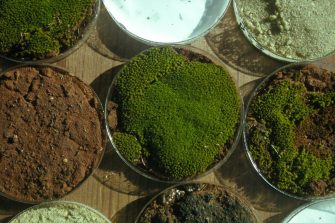

Environmental science and conservation science aim to protect our planet – the natural resources and biodiversity within Earth’s many ecosystems. Research within environmental conservation looks to protect the world’s environments and provide solutions for their long-term sustainability.
At UNSW, honours projects in environmental science and conservation explore Australian environments, seeking to understand natural and human impacts on Earth’s ecosystems, marine, freshwater and terrestrial and their dependent organisms, to identify solutions for management. View our current projects and connect with an honours project supervisor to learn how you can get involved.